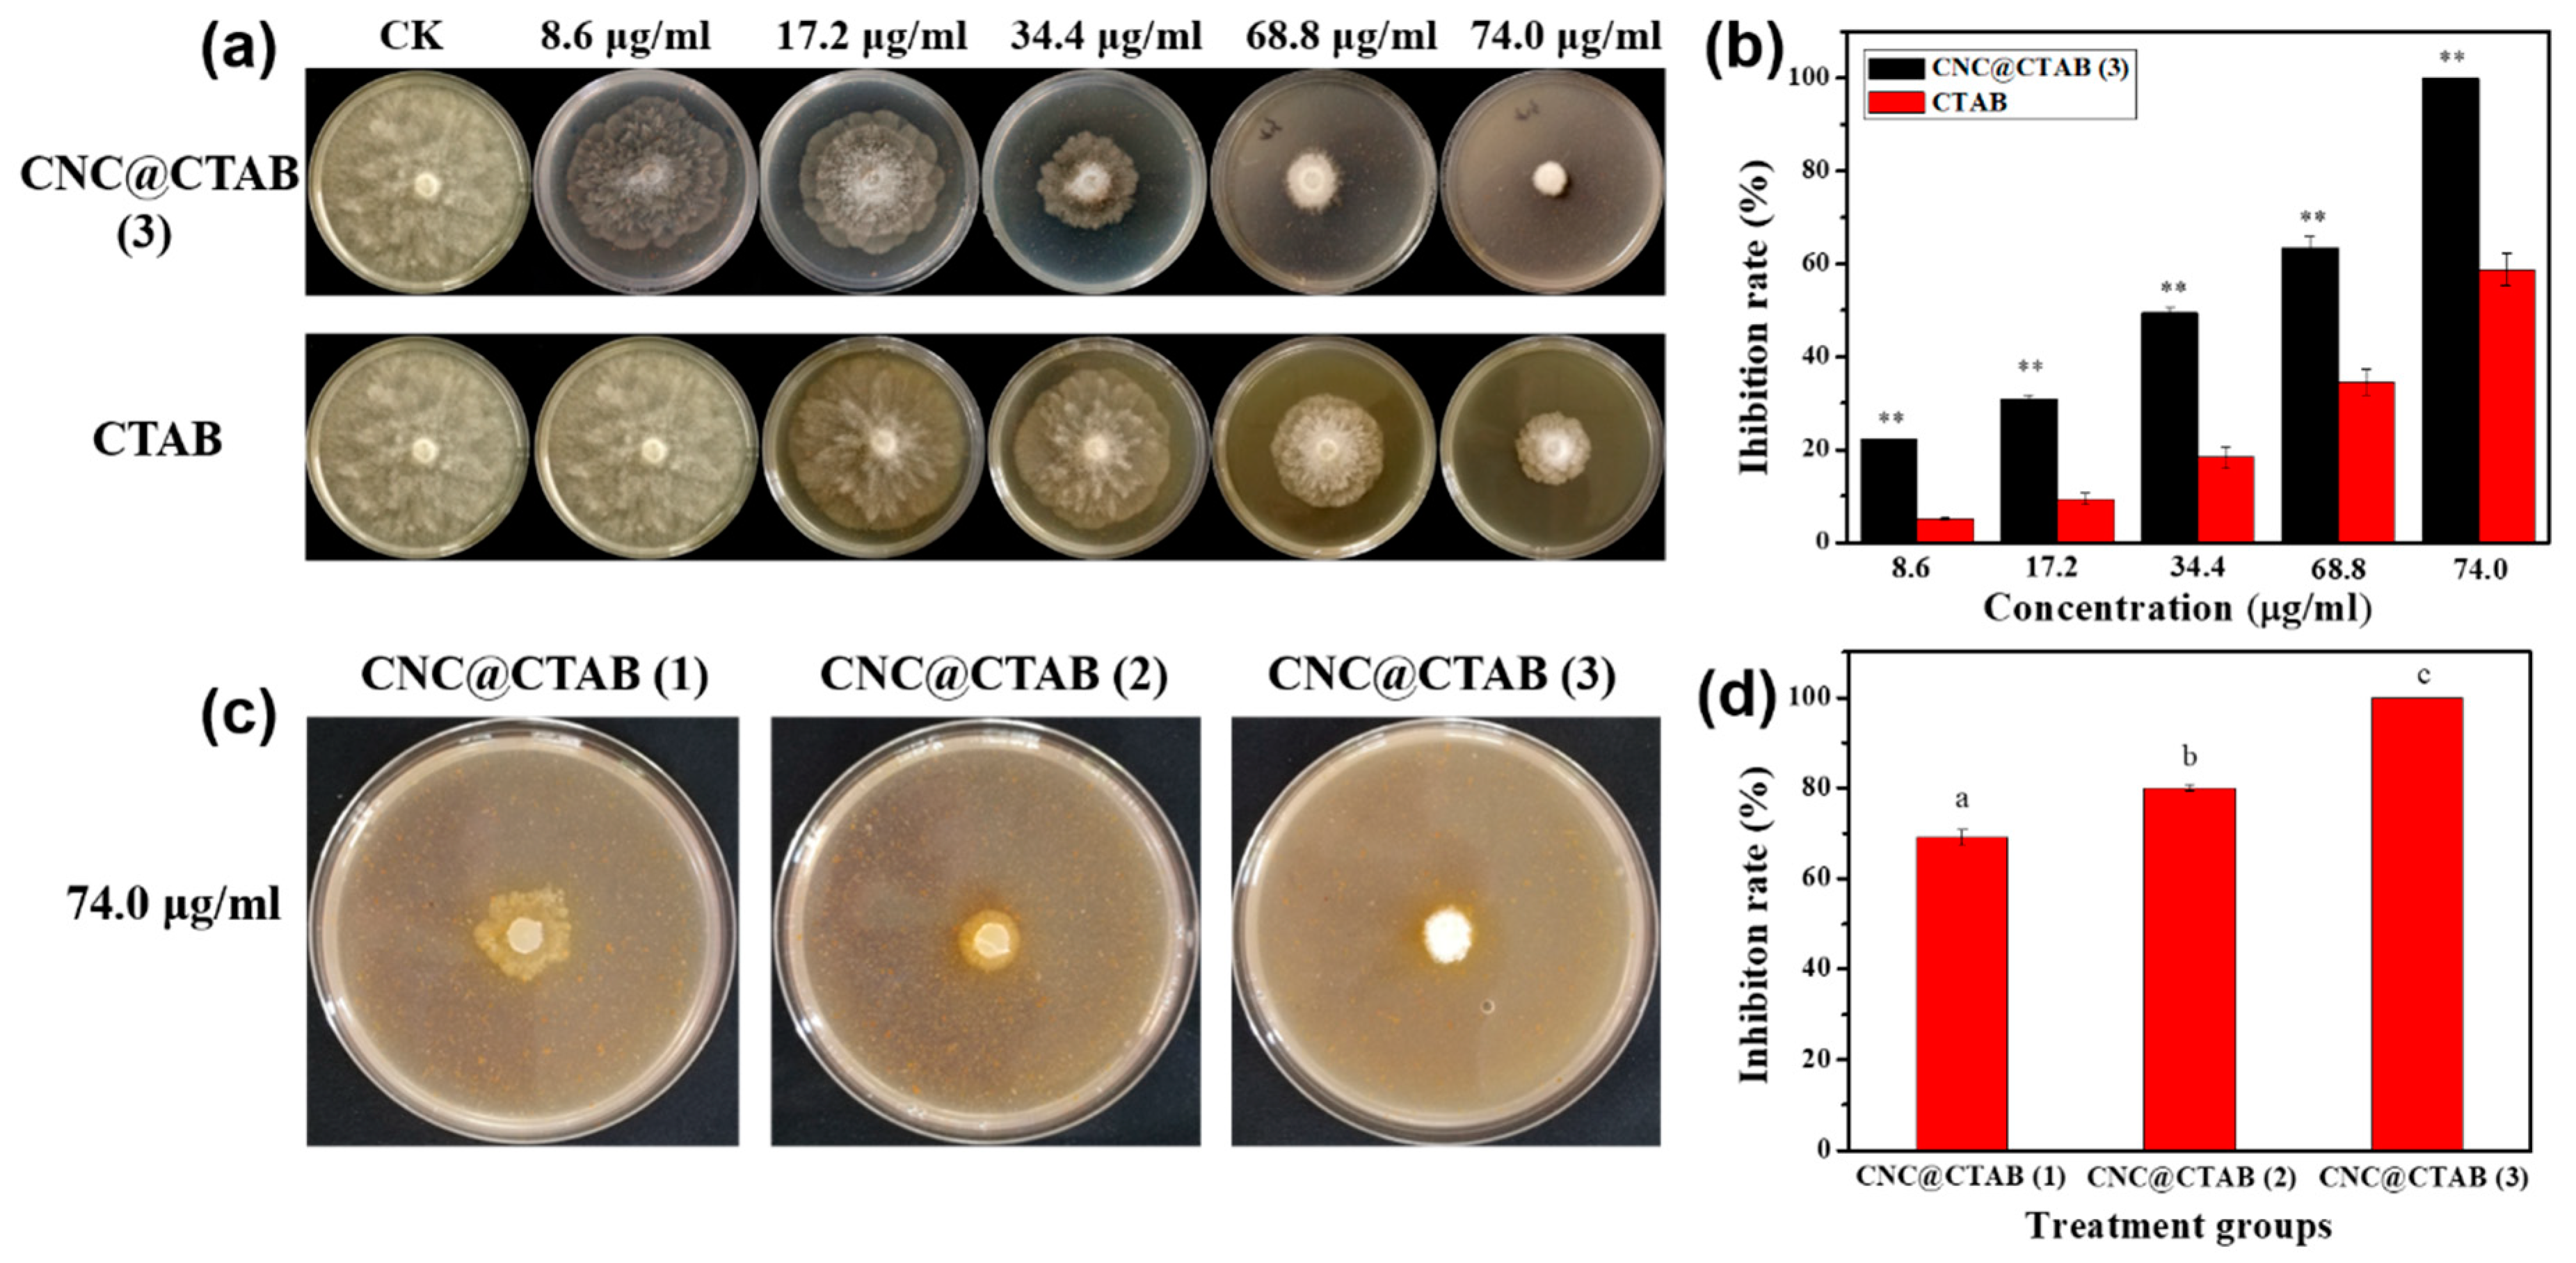
Molecules 24 02467 g002 Molecules 24 02467 g002

Cellulose Nanocrystal Surface Cationization: A New Fungicide with High Activity against Phycomycetes capsici
Abstract
1. Introduction
2. Results and Discussion
2.1. Characterization of CNC and CNC@CTAB
2.2. The Activity of CNC, CTAB, and CNC@CTAB against Phytophthora capsici
2.3. CNC@CTAB Damage Fungal Cell Membrane Permeability
2.4. Inhibition of Pathogens Infecting Pepper Leaves
3. Conclusions
4. Materials and Methods
4.1. Experimental Materials and Instruments
4.2. Sulfuric Acid Extraction of Cellulose Nanocrystal (CNC)
4.3. CNC Grafted Cetyltrimethylammonium Bromide (CTAB) and Its Characterization
4.4. CNC@CTAB against Phytophthora capsici Activity
4.5. Electrical Conductivity Assay of Cell Membrane
4.6. Experiment of Pepper Leaf Infection In Vitro
Supplementary Materials
Author Contributions
Funding
Conflicts of Interest
References
- Wang, Z.; Langston, D.B.; Csinos, A.S.; Gitaitis, R.D.; Walcott, R.R.; Ji, P. Development of an Improved Isolation Approach and Simple Sequence Repeat Markers To Characterize Phytophthora capsici Populations in Irrigation Ponds in Southern Georgia. Appl. Environ. Microbiol. 2009, 75, 5467–5473. [Google Scholar] [CrossRef] [PubMed]
- Lamour, K.H.; Stam, R.; Jupe, J.; Huitema, E. The oomycete broad-host-range pathogen Phytophthora capsici. Mol. Plant Pathol. 2012, 13, 329–337. [Google Scholar] [CrossRef] [PubMed]
- Hausbeck, M.K.; Lamour, K.H. Phytophthora capsici on Vegetable Crops: Research Progress and Management Challenges. Plant Dis. 2004, 88, 1292–1303. [Google Scholar] [CrossRef] [PubMed]
- Ristaino, J.B.; Larkin, R.P.; Campbell, C.L. Spatial and temporal dynamics of Phytophthora epidemics in commercial bell pepper fields. Phytopathology 1993, 83, 1312–1320. [Google Scholar] [CrossRef]
- Parra, G.; Ristaino, J.B. Resistance to mefenoxam and metalaxyl among field isolates of Phytophthora capsici causing phytophthora blight of bell pepper. Plant Dis. 2001, 85, 1069–1075. [Google Scholar] [CrossRef] [PubMed]
- Davidse, L.C.; van den Berg-Velthius, G.C.M.; Mantel, B.C.; Jespers, A.B.K. Phenylamides and Phytophthora. In Phytophthora; Lucas, J.A., Shattock, R.C., Shaw, D.S., Cooke, L.R., Eds.; British Mycological Society: Cambridge, UK, 1991; pp. 349–360. [Google Scholar]
- Judelson, H.S.; Blanco, F.A. The spores of Phytophthora: Weapons of the plant destroyer. Nat. Rev. Microbiol. 2005, 3, 47–58. [Google Scholar] [CrossRef]
- Kuhajek, J.M.; Jeffers, S.N.; Slattery, M.; Wedge, D.E. A Rapid Microbioassay for Discovery of Novel Fungicides for Phytophthora spp. Phytopathology 2003, 93, 46–53. [Google Scholar] [CrossRef]
- Ricci, P.; Bonnet, P.; Huet, J.C.; Sallantin, M.; Beauvais-Cante, F.; Bruneteau, M.; Billard, V.; Michel, G.; Pernollet, J.C. Structure and activity of proteins from pathogenic fungi Phytophthora eliciting necrosis and acquired resistance in tobacco. FEBS J. 2010, 183, 555–563. [Google Scholar] [CrossRef]
- Jung Yeop, L.; Byung Kook, H. Diversity of antifungal actinomycetes in various vegetative soils of Korea. Re-Vue Can. De Microbiol. 2002, 48, 407–417. [Google Scholar]
- Pang, Z.; Shao, J.; Chen, L.; Lu, X.; Hu, J.; Qin, Z.; Liu, X. Resistance to the Novel Fungicide Pyrimorph in Phy-tophthora capsici: Risk Assessment and Detection of Point Mutations in CesA3 That Confer Resistance. PLoS ONE 2013, 8, e56513. [Google Scholar] [CrossRef]
- Stein, J.M.; Kirk, W.W. The generation and quantification of resistance to dimethomorph in Phytophthora infestans. Plant Dis. 2004, 88, 930–934. [Google Scholar] [CrossRef] [PubMed]
- Huang, L.H.; Liu, J.L.; Nai-Guo, S.I.; Zhang, Z.J.; Chen, L. Studies on Phytophthora capsici Resistance to Flumorph. Pesticides 2004, 6. [Google Scholar]
- Meng, Q.X.; Cui, X.L.; Bi, Y.; Wang, Q.; Hao, J.J.; Liu, X.L. Biological and genetic characterization of Phytophthora capsici mutants resistant to flumorph. Plant Pathol. 2011, 60, 957–966. [Google Scholar] [CrossRef]
- Lan, Q.; Yang, F.; Zhang, S.; Liu, S.; Xu, J.; Sun, D. Synergistic effect of silica nanoparticle and cetyltrimethyl ammonium bromide on the stabilization of O/W emulsions. Colloids Surf. A Physicochem. Eng. Asp. 2007, 302, 126–135. [Google Scholar] [CrossRef]
- Vigderman, L.; Manna, P.; Zubarev, E.R. Quantitative replacement of cetyl trimethylammonium bromide by cationic thiol ligands on the surface of gold nanorods and their extremely large uptake by cancer cells. Angew. Chem. Int. Ed. 2012, 124, 660–665. [Google Scholar] [CrossRef]
- Hoogerheide, J.C. The Germicidal Properties of Certain Quarternary Ammonium Salts With Special Reference to Cetyl-Trimethyl-Ammonium Bromide. J. Bacteriol. 1945, 49, 277–289. [Google Scholar]
- Cheng, L.; Weir, M.D.; Zhang, K.; Xu, S.M.; Chen, Q.; Zhou, X.; Xu, H.H.K. Antifungal Nanocomposite with Calcium Phosphate and Quaternary Ammonium. J. Dent. Res. 2012, 91, 460–466. [Google Scholar] [CrossRef]
- Dong, C.; You, W.; Liuyang, R.; Lei, Y.; Zhang, A.; Lin, Y. Anti- Rhizoctonia solani activity by polymeric qua-ternary ammonium salt and its mechanism of action. React. Funct. Polym. 2018, 125, 1–10. [Google Scholar] [CrossRef]
- Yan, X.B.; Gu, Y.H.; Huang, D.; Gan, L.; Wu, L.X.; Huang, L.H.; Chen, Z.D.; Huang, S.O.; Zhou, K.C. Binding tendency with oligonucleotides and cell toxicity of cetyltrimethyl ammonium bromide-coated single-walled carbon nanotubes. Trans. Nonferrous Met. Soc. China 2011, 21, 1085–1091. [Google Scholar] [CrossRef]
- Garoma, T.; Kocher, J. Investigation of surfactant-modified activated carbon for recycled water disinfection. Water Sci. Technol. A J. Int. Assoc. Water Pollut. Res. 2010, 62, 1755–1766. [Google Scholar] [CrossRef]
- Banerjee, I.; Pangule, R.C.; Kane, R.S. Antifouling coatings: Recent developments in the design of surfaces that prevent fouling by proteins, bacteria, and marine organisms. Adv. Mater. 2011, 23, 690–718. [Google Scholar] [CrossRef] [PubMed]
- Senuma, M.; Tashiro, T.; Iwakura, M.; Kaeriyama, K.; Shimura, Y. Synthesis and antibacterial activity of copolymers having a quaternary ammonium salt side group. J. Appl. Polym. Sci. 2010, 37, 2837–2843. [Google Scholar] [CrossRef]
- Bespalova, Y.; Kwon, D.; Vasanthan, N. Surface modification and antimicrobial properties of cellulose nanocrystals. J. Appl. Polym. Sci. 2017, 134. [Google Scholar] [CrossRef]
- Lu, Q.X.; Fu, S.Z.; Yin, B.L.; Tao, W.M.; Dou, J.L.; Wei, X.L. Synthesis and Properties of Quaternary Ammonium Gemini Surfactants. Green Technol. 2011, 2011, 176–179. (In Chinese) [Google Scholar]
- Khan, M.S.; Pandey, S.; Bhaisare, M.L.; Gedda, G.; Talib, A.; Wu, H.F. Graphene oxide@gold nanorods for chemo-photothermal treatment and controlled release of doxorubicin in mice Tumor. Colloids Surf. B Biointerfaces 2017, 160, 543–552. [Google Scholar] [CrossRef] [PubMed]
- Favi, P.M.; Valencia, M.M.; Elliott, P.R.; Restrepo, A.; Gao, M.; Huang, H.; Pavon, J.J.; Webster, T.J. Shape and surface chemistry effects on the cytotoxicity and cellular uptake of metallic nanorods and nanospheres. J. Biomed. Mater. Res. Part A 2015, 103, 3940–3955. [Google Scholar] [CrossRef]
- Moon, R.J.; Martini, A.; Nairn, J.; Simonsen, J.; Youngblood, J. ChemInform Abstract: Cellulose Nanomaterials Review: Structure, Properties and Nanocomposites. Chem. Soc. Rev. 2011, 40, 3941–3994. [Google Scholar] [CrossRef] [PubMed]
- Youssef, H.; Lucia, L.A.; Rojas, O.J. Cellulose nanocrystals: Chemistry, self-assembly, and applications. Chem. Rev. 2010, 110, 3479–3500. [Google Scholar]
- Mahmoud, K.A.; Mena, J.A.; Male, K.B.; Kamen, A.; Hrapovic, S.; Luong, J.H.T. Effect of surface charge on the cellular uptake and cytotoxicity of fluorescent labeled cellulose nanocrystals. ACS Appl. Mater. Interfaces 2010, 2, 2924–2932. [Google Scholar] [CrossRef]
- Ning, L.; Dufresne, A. Nanocellulose in biomedicine: Current status and future prospect. Eur. Polym. J. 2014, 59, 302–325. [Google Scholar]
- Jorfi, M.; Foster, E.J. Recent Advances in Nanocellulose for Biomedical Applications. J. Appl. Polym. Sci. 2015, 132, 41719. [Google Scholar] [CrossRef]
- Nechyporchuk, O.; Belgacem, M.N.; Bras, J. Production of cellulose nanofibrils: A review of recent advances. Ind. Crop. Prod. 2016, 93, 2–25. [Google Scholar] [CrossRef]
- Salas, C.; Nypelö, T.; Rodriguez-Abreu, C.; Carrillo, C.; Rojas, O.J. Nanocellulose properties and applications in colloids and interfaces. Curr. Opin. Colloid Interface Sci. 2014, 19, 383–396. [Google Scholar] [CrossRef]
- Tang, J.; Sisler, J.; Grishkewich, N.; Tam, K.C. Functionalization of cellulose nanocrystals for advanced applications. J. Colloid Interface Sci. 2017, 494, 397–409. [Google Scholar] [CrossRef] [PubMed]
- Kaboorani, A.; Ried, B. Surface modification of cellulose nanocrystals (CNC) by a cationic surfactant. Ind. Crop. Prod. 2015, 65, 45–55. [Google Scholar] [CrossRef]
- Rehman, N.; Bica, C.I.; de Miranda, M.I.G.; Rosa, S.M. Dynamics of cellulose nanocrystals in the presence of hexadecyltrimethylammonium bromide. Macromol. Res. 2017, 25, 1–5. [Google Scholar] [CrossRef]
- Nagalakshmaiah, M.; El, K.N.; Dufresne, A. Ionic Compatibilization of Cellulose Nanocrystals with Quaternary Ammonium Salt and Their Melt Extrusion with Polypropylene. ACS Appl. Mater. Interfaces 2016, 8, 8755–8764. [Google Scholar] [CrossRef]
- Yalcinkaya, E.E.; Puglia, D.; Fortunati, E.; Bertoglio, F.; Bruni, G.; Visai, L.; Kenny, J.M. Cellulose nanocrystals as templates for cetyltrimethylammonium bromide mediated synthesis of Ag nanoparticles and their novel use in PLA films. Carbohydr. Polym. 2017, 157, 1557–1567. [Google Scholar] [CrossRef]
- Gorelikov, I.; Matsuura, N. Single-step coating of mesoporous silica on cetyltrimethyl ammonium bromide-capped nanoparticles. Nano Lett. 2008, 8, 369–373. [Google Scholar] [CrossRef]
- Yu, Y.; Xin, G.; Jiang, Z.; Zhang, W.; Ma, J.; Liu, X.; Zhang, L. Homogeneous grafting of cellulose with poly-caprolactone using quaternary ammonium salt systems and its application for ultraviolet-shielding composite films. RSC Adv. 2018, 8, 10865–10872. [Google Scholar] [CrossRef]
- Hasani, M.; Cranston, E.D.; Westman, G.; Gray, D.G. Cationic surface functionalization of cellulose nanocrystals. Soft Matter 2008, 4, 2238–2244. [Google Scholar] [CrossRef]
- Huang, L.; Ye, Z.; Berry, R. Modification of Cellulose Nanocrystals with QuaternaryAmmonium-Containing Hyperbranched Polyethylene Ionomers by Ionic Assembly. ACS Sustain. Chem. Eng. 2016, 4, 4937–4950. [Google Scholar] [CrossRef]
- Zoppe, J.O.; Peresin, M.S.; Habibi, Y.; Venditti, R.A.; Rojas, O.J. Reinforcing Poly(ε-caprolactone) Nanofibers with Cellulose Nanocrystals. ACS Appl. Mater. Interfaces 2009, 1, 1996–2004. [Google Scholar] [CrossRef] [PubMed]
- Mangalam, A.P.; Simonsen, J.; Benight, A.S. Cellulose/DNA Hybrid Nanomaterials. Biomacromolecules 2009, 10, 497–504. [Google Scholar] [CrossRef] [PubMed]
- Firoz, M.J.; Xiao, X.; Zhu, F.X.; Fu, Y.P.; Jiang, D.H.; Schnabel, G.; Luo, C.X. Exploring mechanisms of resistance to dimethachlone in Sclerotinia sclerotiorum. Pest Manag. Sci. 2015, 72, 770–779. [Google Scholar] [CrossRef]
Sample Availability: Samples of the compounds CNC@CTAB are available from the authors. |

| Name | Feed Ratio | Zeta Potential | Elemental Analysis | CTAB Surface Density |
|---|---|---|---|---|
| (CNC:CTAB) | (mV) | (N%) | (nmol/cm2) | |
| CNC | 0 | −39.4 ± 0.70 | 0 | 0 |
| CNC@CTAB (1) | 2.50% | −9.5 ± 0.45 | 0.1 ± 0.03 | 2.86 × 10−2 |
| CNC@CTAB (2) | 5.00% | +2.4 ± 0.23 | 0.14 ± 0.05 | 3.96 × 10−2 |
| CNC@CTAB (3) | 10.00% | +7.7 ± 0.32 | 0.19 ± 0.03 | 5.50 × 10−2 |
| Name | Disease Index |
|---|---|
| CK | 16.7 d |
| CNC | 16.7 d |
| CTAB | 13 c |
| CNC@CTAB (1) | 1.5 b |
| CNC@CTAB (2) | 0 a |
| CNC@CTAB (3) | 0 a |
| Level | Degree of Disease |
|---|---|
| 0 | No disease |
| 1 | The lesions account for less than 10% of the surface area of the leaf |
| 3 | The lesions account for 11–30% of the surface area of the leaf |
| 5 | The lesions account for 31–50% of the surface area of the leaf |
| 7 | The lesions account for 51–75% of the surface area of the leaf |
| 9 | The lesions account for more than 75% of the surface area of the leaf |
© 2019 by the authors. Licensee MDPI, Basel, Switzerland. This article is an open access article distributed under the terms and conditions of the Creative Commons Attribution (CC BY) license (http://creativecommons.org/licenses/by/4.0/).
Share and Cite
Xiang, S.; Ma, X.; Liao, S.; Shi, H.; Liu, C.; Shen, Y.; Lv, X.; Yuan, M.; Fan, G.; Huang, J.; et al. Cellulose Nanocrystal Surface Cationization: A New Fungicide with High Activity against Phycomycetes capsici. Molecules 2019, 24, 2467. https://doi.org/10.3390/molecules24132467
Xiang S, Ma X, Liao S, Shi H, Liu C, Shen Y, Lv X, Yuan M, Fan G, Huang J, et al. Cellulose Nanocrystal Surface Cationization: A New Fungicide with High Activity against Phycomycetes capsici. Molecules. 2019; 24(13):2467. https://doi.org/10.3390/molecules24132467
Chicago/Turabian StyleXiang, Shunyu, Xiaozhou Ma, Shuyue Liao, Huan Shi, Changyun Liu, Yang Shen, Xing Lv, Mengting Yuan, Guangjin Fan, Jin Huang, and et al. 2019. "Cellulose Nanocrystal Surface Cationization: A New Fungicide with High Activity against Phycomycetes capsici" Molecules 24, no. 13: 2467. https://doi.org/10.3390/molecules24132467
APA StyleXiang, S., Ma, X., Liao, S., Shi, H., Liu, C., Shen, Y., Lv, X., Yuan, M., Fan, G., Huang, J., & Sun, X. (2019). Cellulose Nanocrystal Surface Cationization: A New Fungicide with High Activity against Phycomycetes capsici. Molecules, 24(13), 2467. https://doi.org/10.3390/molecules24132467
